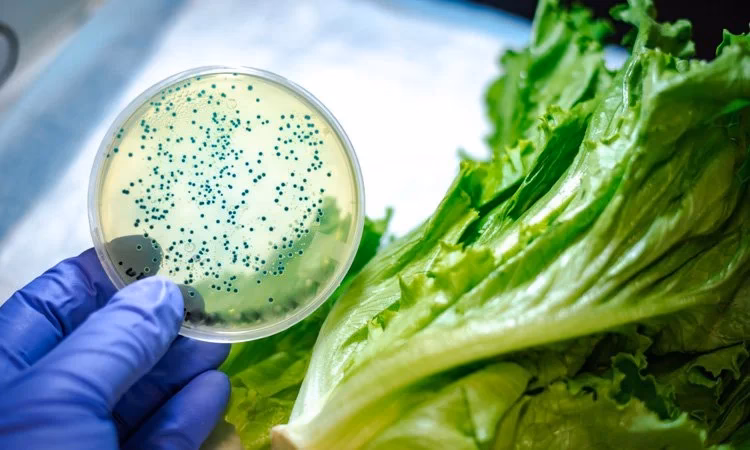
What contaminates the coast?

08/07/2010
La contaminación es un problema que a menudo asociamos con imágenes impactantes: ríos teñidos de colores extraños por desechos industriales, costas cubiertas de plástico o ciudades envueltas en una densa nube de esmog. Sin embargo, una de las formas más insidiosas y peligrosas de contaminación es invisible a nuestros ojos y puede estar presente en nuestra propia mesa. Hablamos de la contaminación de los alimentos por micotoxinas, compuestos tóxicos producidos por ciertos tipos de moho que crecen en los cultivos y que representan una amenaza constante para la salud pública mundial y la seguridad alimentaria.

Este problema es silencioso pero masivo. Se estima que aproximadamente el 25% de los cultivos cosechados en el mundo están contaminados por micotoxinas cada año, lo que genera pérdidas agrícolas y económicas de miles de millones de dólares. Pero más allá del impacto económico, el verdadero riesgo reside en los efectos crónicos y agudos que estas toxinas pueden tener en la salud humana y animal. Acompáñanos a desvelar qué son exactamente, dónde se encuentran y cómo podemos enfrentar este desafío global.
¿Qué son Exactamente las Micotoxinas?
Las micotoxinas son metabolitos secundarios tóxicos producidos por hongos filamentosos (comúnmente conocidos como mohos) que pueden crecer en una amplia variedad de cultivos y alimentos. El término proviene del griego "mykes" (hongo) y "toxikon" (veneno). No todos los mohos producen micotoxinas, pero los que sí lo hacen pertenecen principalmente a tres géneros: Aspergillus, Fusarium y Penicillium.

Estos hongos pueden contaminar los cultivos en dos momentos clave:
- Pre-cosecha: Mientras la planta todavía está creciendo en el campo, las condiciones climáticas como la alta humedad y temperaturas específicas pueden favorecer la infección por hongos.
- Post-cosecha: Durante el almacenamiento, transporte o procesamiento de los alimentos, si las condiciones de humedad y temperatura no son las adecuadas, los mohos pueden proliferar y producir estas toxinas.
Una de las características más preocupantes de las micotoxinas es su increíble estabilidad. Son resistentes a altas temperaturas y a muchos procesos de elaboración de alimentos como la cocción, el horneado o la pasteurización. Esto significa que, aunque el hongo que las produjo haya sido eliminado, la toxina puede permanecer en el producto final. Además, la amenaza no se detiene en los cultivos; cuando los animales consumen piensos contaminados, las micotoxinas pueden acumularse en sus tejidos o ser transferidas a productos derivados como la carne, la leche y los huevos, ingresando así a la cadena alimentaria humana de forma indirecta.
Los Tipos de Micotoxinas Más Comunes y Peligrosos
Se han identificado más de 300 micotoxinas, pero un pequeño grupo es responsable de la mayoría de los problemas de seguridad alimentaria a nivel mundial. A continuación, detallamos las más relevantes.
Aflatoxinas (AFs)
Consideradas las más tóxicas y estudiadas, las aflatoxinas son producidas principalmente por las especies Aspergillus flavus y Aspergillus parasiticus. Son potentes agentes hepatotóxicos y han sido clasificadas por la Agencia Internacional para la Investigación del Cáncer (IARC) como carcinógenos del Grupo 1, lo que significa que hay evidencia suficiente de que causan cáncer en humanos, específicamente carcinoma hepatocelular (cáncer de hígado). Los alimentos más comúnmente contaminados son el maíz, los cacahuetes, los frutos secos (pistachos, almendras), las especias y el algodón. Una forma derivada, la Aflatoxina M1, puede encontrarse en la leche de vacas que han consumido pienso contaminado con Aflatoxina B1.

Ocratoxina A (OTA)
Producida por especies de Aspergillus y Penicillium, la Ocratoxina A se encuentra en una gran variedad de productos como cereales (trigo, cebada), café, cacao, vino, uvas pasas y algunas carnes. Su principal efecto tóxico es sobre los riñones (nefrotóxica) y se sospecha que está implicada en la Nefropatía Endémica de los Balcanes, una enfermedad renal crónica. La IARC la clasifica como un posible carcinógeno para los humanos (Grupo 2B).
Fumonisinas
Descubiertas en 1988, son producidas por hongos del género Fusarium, especialmente Fusarium verticillioides, un contaminante muy común del maíz a nivel mundial. La Fumonisin B1 es la más prevalente y tóxica. Su mecanismo de acción consiste en alterar el metabolismo de los esfingolípidos, componentes esenciales de las membranas celulares. En animales, han demostrado causar leucoencefalomalacia en caballos y edema pulmonar en cerdos. En humanos, están asociadas con un mayor riesgo de cáncer de esófago y defectos del tubo neural en recién nacidos. La IARC las clasifica como posibles carcinógenos (Grupo 2B).
Zearalenona (ZEA)
También producida por el género Fusarium, la Zearalenona se encuentra frecuentemente en el maíz, trigo, cebada y otros cereales. Su estructura química es similar a la de los estrógenos, por lo que actúa como un disruptor endocrino, causando efectos estrogénicos. En animales, especialmente en cerdos, provoca problemas reproductivos como infertilidad, hinchazón de la vulva y atrofia de los ovarios. Su impacto en la salud humana sigue siendo objeto de estudio, pero la preocupación por su actividad hormonal es alta.
Tricotecenos (e.g., Deoxinivalenol - DON)
Este es un gran grupo de micotoxinas producidas por varias especies de Fusarium. El Deoxinivalenol (DON), también conocido como vomitoxina, es el más común en cereales como el trigo y la cebada, a menudo como resultado de la fusariosis de la espiga, una enfermedad devastadora para los cultivos. En humanos, la exposición aguda a DON puede causar síntomas gastrointestinales agudos como náuseas, vómitos, diarrea y dolor abdominal. En animales, provoca rechazo del alimento, reducción del aumento de peso y supresión del sistema inmunológico, haciéndolos más susceptibles a otras enfermedades.
Tabla Comparativa de Micotoxinas Principales
| Micotoxina | Hongo Productor Principal | Alimentos Comúnmente Afectados | Principales Efectos en la Salud |
|---|---|---|---|
| Aflatoxinas | Aspergillus flavus, A. parasiticus | Maíz, cacahuetes, frutos secos, especias, leche (M1) | Altamente cancerígenas (hígado), hepatotóxicas, inmunosupresoras. |
| Ocratoxina A | Aspergillus ochraceus, Penicillium verrucosum | Cereales, café, vino, cacao, uvas pasas | Nefrotóxica (daño renal), posible carcinógeno. |
| Fumonisinas | Fusarium verticillioides, F. proliferatum | Maíz y productos derivados del maíz | Posible carcinógeno, neurotóxica, hepatotóxica. |
| Zearalenona | Fusarium graminearum | Maíz, trigo, cebada, centeno | Disruptor endocrino (efectos estrogénicos), problemas reproductivos. |
| Deoxinivalenol (DON) | Fusarium graminearum, F. culmorum | Trigo, maíz, cebada, avena | Toxicidad gastrointestinal aguda (vómitos), inmunosupresión. |
Preguntas Frecuentes (FAQ) sobre Micotoxinas
¿Cocinar los alimentos elimina las micotoxinas?
Lamentablemente, no. La gran mayoría de las micotoxinas son termoestables, lo que significa que resisten los procesos de cocción habituales como hervir, hornear o freír. Por lo tanto, si un alimento está contaminado, cocinarlo no lo hará seguro para el consumo.

¿Puedo simplemente quitar la parte con moho de un alimento y comerme el resto?
No es recomendable. El moho visible en la superficie es solo una parte del hongo; sus raíces, llamadas hifas, pueden penetrar profundamente en el alimento. Además, si el moho es un productor de micotoxinas, estas pueden haberse difundido por todo el producto, incluso en las partes que parecen estar en buen estado. La recomendación de seguridad es desechar todo el alimento.
¿Todos los mohos en los alimentos son peligrosos?
No, no todos los mohos producen micotoxinas. Algunos se utilizan deliberadamente en la producción de alimentos, como los quesos azules (Penicillium roqueforti). Sin embargo, a simple vista es imposible distinguir un moho inofensivo de uno tóxico. Por precaución, se debe evitar el consumo de cualquier alimento que haya desarrollado moho de forma no intencionada.

¿Qué se está haciendo para controlar este problema?
Organismos internacionales y agencias gubernamentales como la FDA en Estados Unidos y la EFSA en Europa establecen límites máximos estrictos para las principales micotoxinas en alimentos y piensos. Se invierte en investigación para desarrollar mejores métodos de detección, así como prácticas agrícolas (como la rotación de cultivos y el uso de variedades resistentes) y de almacenamiento que minimicen el crecimiento de hongos y la producción de toxinas.
¿Pueden las micotoxinas pasar a la carne, leche o huevos?
Sí. Este proceso se conoce como "carry-over". Cuando los animales de granja consumen piensos contaminados, algunas micotoxinas pueden ser absorbidas, metabolizadas y depositadas en tejidos comestibles (carne) o excretadas en productos como la leche y los huevos. La Aflatoxina M1 en la leche es el ejemplo más conocido y regulado de este fenómeno.
Si quieres conocer otros artículos parecidos a Micotoxinas: El Peligro Oculto en Alimentos puedes visitar la categoría Contaminación.
